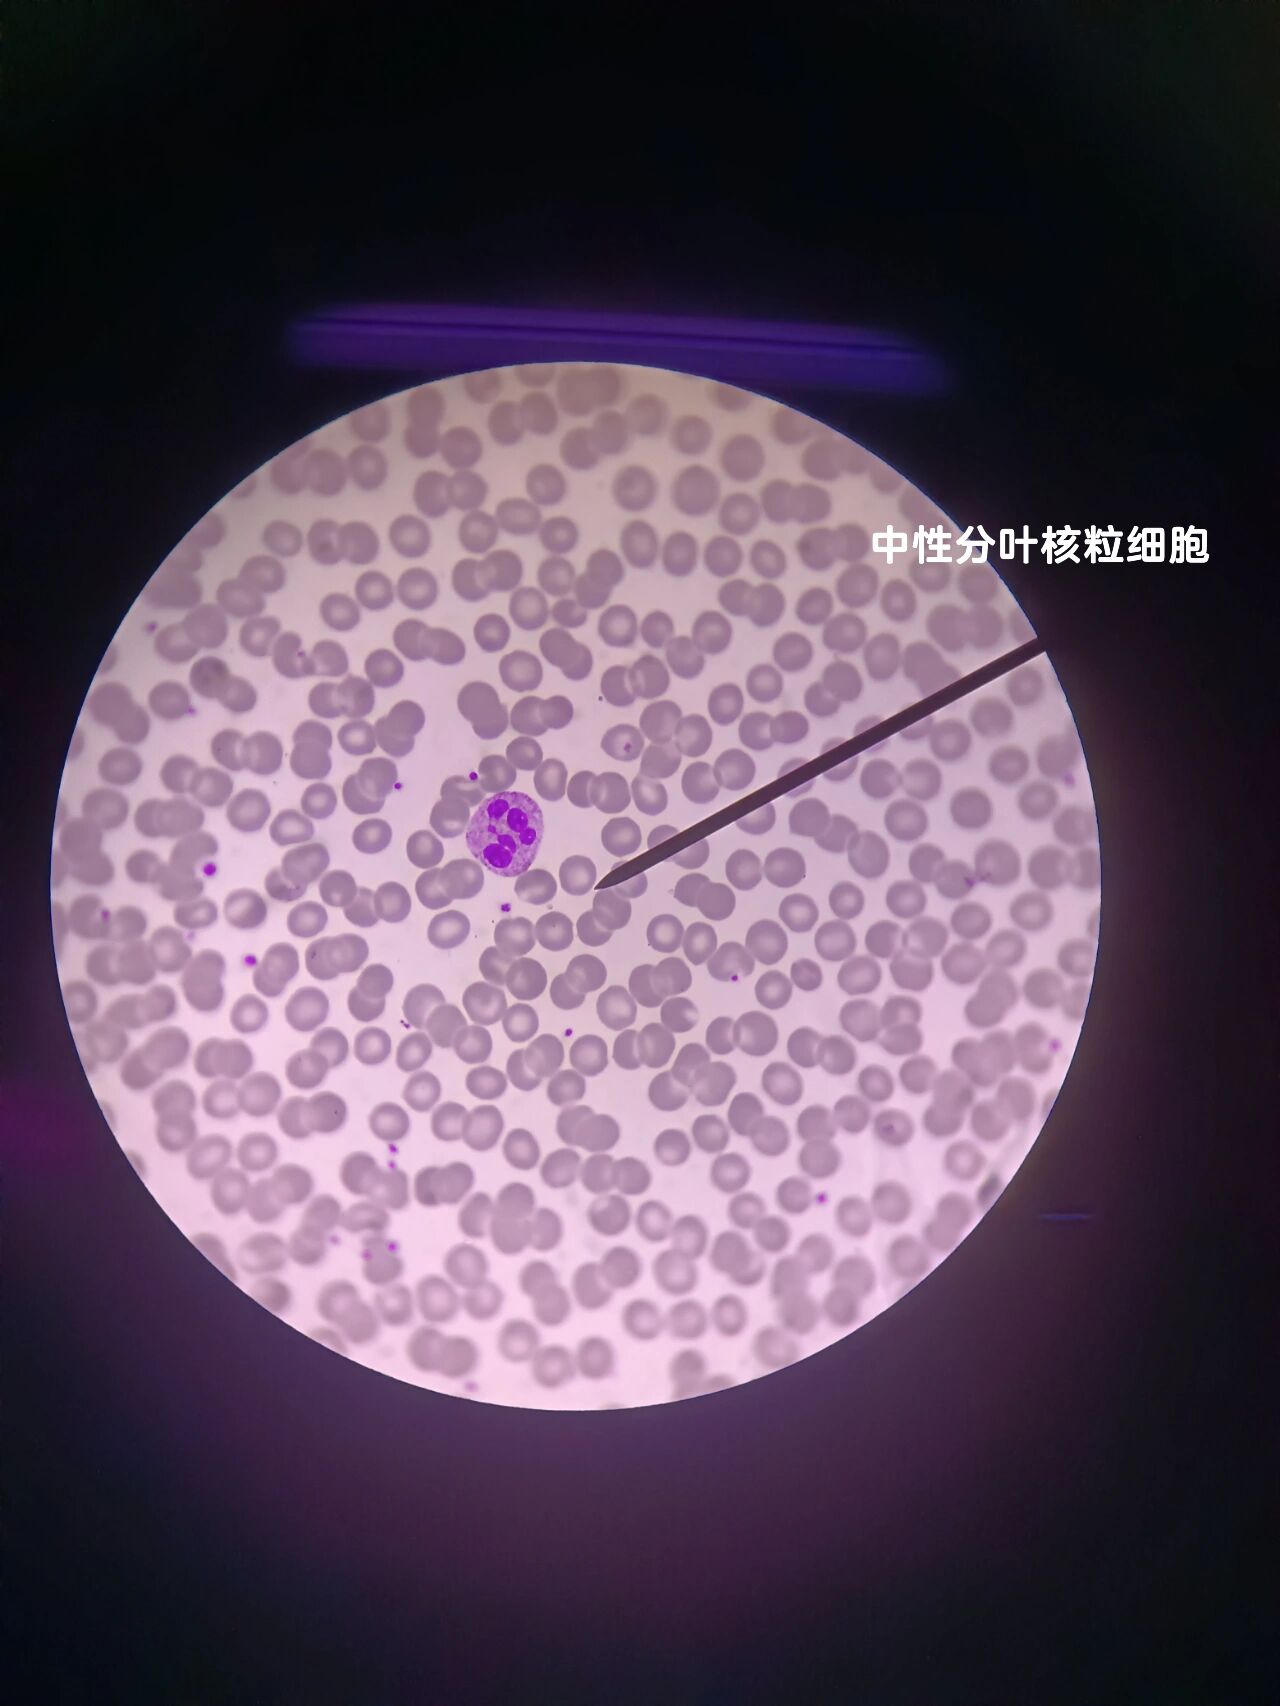
白细胞多少为正常

本文将详细介绍《DNF疲劳药水领取大全》,为广大地下城与勇士(DNF)玩家提供全面的药水领取信息。疲劳药水是DNF中非常重要的道具,能够有效地缓解玩家在日常副本中的疲劳度,帮助玩家提升游戏体验。本文将从不同角度分析疲劳药水的获取方式,使用注意事项,领取策略等方面,帮助玩家们更好地管理游戏资源,提升游戏效率。
一、疲劳药水的基本介绍
1、疲劳药水是《地下城与勇士》(DNF)中一项非常实用的道具。玩家在进行副本挑战时,随着战斗的进行,会逐渐积累疲劳。疲劳度的提升会限制玩家进行副本的次数,而疲劳药水可以帮助玩家恢复疲劳度,继续进行游戏。通过使用疲劳药水,玩家能够保持高效的刷副本进度,从而获得更多的游戏资源和奖励。
2、在《DNF》中,玩家的每日挑战次数受到疲劳度的影响。每当疲劳度达到一定程度后,玩家就无法再继续挑战副本。疲劳药水能够有效解决这一问题,通过恢复疲劳度,玩家可以继续进行高效率的游戏玩法。这不仅可以帮助玩家提升等级、装备,还能获得更多的副本奖励。
3、疲劳药水的使用范围较为广泛,几乎适用于所有日常副本和挑战内容。无论是团队副本还是单人副本,玩家都能通过合理使用疲劳药水,提高副本通关效率。此外,疲劳药水的种类也很多,玩家可以根据自己的需求选择不同类型的药水。
二、如何获取疲劳药水
1、在《DNF》中,获取疲劳药水的途径有很多种。首先,玩家可以通过每日签到获得一定数量的疲劳药水。这是游戏官方为玩家提供的一种福利,帮助玩家维持日常游戏节奏。每天登录游戏并完成指定任务后,玩家就能领取到疲劳药水。
2、除了每日签到,玩家还可以通过参与特定的活动来获取疲劳药水。例如,节假日或者重大版本更新期间,官方通常会推出一些限时活动,通过完成这些活动,玩家可以获得大量的疲劳药水。此外,某些充值活动也会提供疲劳药水作为奖励。
3、玩家还可以通过商城购买疲劳药水。在《DNF》的商城中,玩家可以使用点券购买各种类型的疲劳药水,包括单次使用的和永久使用的药水。商城购买的疲劳药水数量较为丰富,且不受每日领取次数的限制,因此这是一种非常直接的获取途径。
三、疲劳药水的使用策略
1、尽量在副本挑战的高峰时段使用疲劳药水。由于疲劳度在每日的副本挑战中逐渐累积,玩家可以根据自身的游戏计划,选择在需要大量挑战副本时使用疲劳药水。这样一来,可以最大化疲劳药水的效益,确保玩家在关键时刻不受疲劳度限制。
2、合理规划疲劳药水的使用时间。在一些特殊的活动或者高奖励的副本挑战中,玩家往往需要大量的挑战次数,这时使用疲劳药水显得尤为重要。然而,玩家也要避免盲目使用药水,以免过早用尽。在每天的游戏中,合理分配疲劳药水的使用时间,能够保证玩家在长期游戏中持续有足够的挑战机会。
3、结合其他游戏道具使用疲劳药水。除了疲劳药水,《DNF》中的一些道具也能够帮助玩家提升副本效率,如经验加成道具、掉落加成道具等。玩家可以将疲劳药水与其他道具合理搭配使用,以获得最佳的游戏收益。
四、疲劳药水的注意事项
1、疲劳药水的使用需要谨慎。虽然疲劳药水能够有效地恢复玩家的疲劳度,但它也并不是无限制的使用资源。玩家在使用疲劳药水时,应该根据实际需求和副本难度来进行选择,避免在不必要的时候浪费资源。
2、过度依赖疲劳药水可能导致游戏体验的单一性。虽然疲劳药水能够帮助玩家快速恢复疲劳,但如果玩家过度依赖药水,而忽视了其他游戏内容的丰富性和多样性,可能会导致游戏体验的单调。因此,玩家应该在保证游戏多样性的前提下,合理使用疲劳药水。
3、某些疲劳药水有使用次数限制。虽然疲劳药水的种类很多,但其中一些药水只能够在特定的时间段内使用,或者仅限每日使用次数。因此,玩家在购买或领取疲劳药水时,应该仔细查看使用规则,以免错过最佳使用时机。
五、总结:
本文介绍了《DNF疲劳药水领取大全》的各个方面,包括疲劳药水的基本介绍、获取途径、使用策略和注意事项。疲劳药水作为《DNF》中的重要道具,能够帮助玩家保持游戏的高效进行,并且提升副本挑战的效率。合理使用疲劳药水,不仅能提升玩家的游戏体验,还能让玩家在繁忙的日常任务中获得更多的成就感。希望通过本文,玩家们能够更好地掌握疲劳药水的使用技巧,提升自己的游戏表现。
本文由发布,如无特别说明文章均为原创,请勿采集、转载、复制。
转载请注明来自极限财经,本文标题:《dnf疲劳药水领取大全》

京公网安备11000000000001号
京ICP备11000001号
还没有评论,来说两句吧...